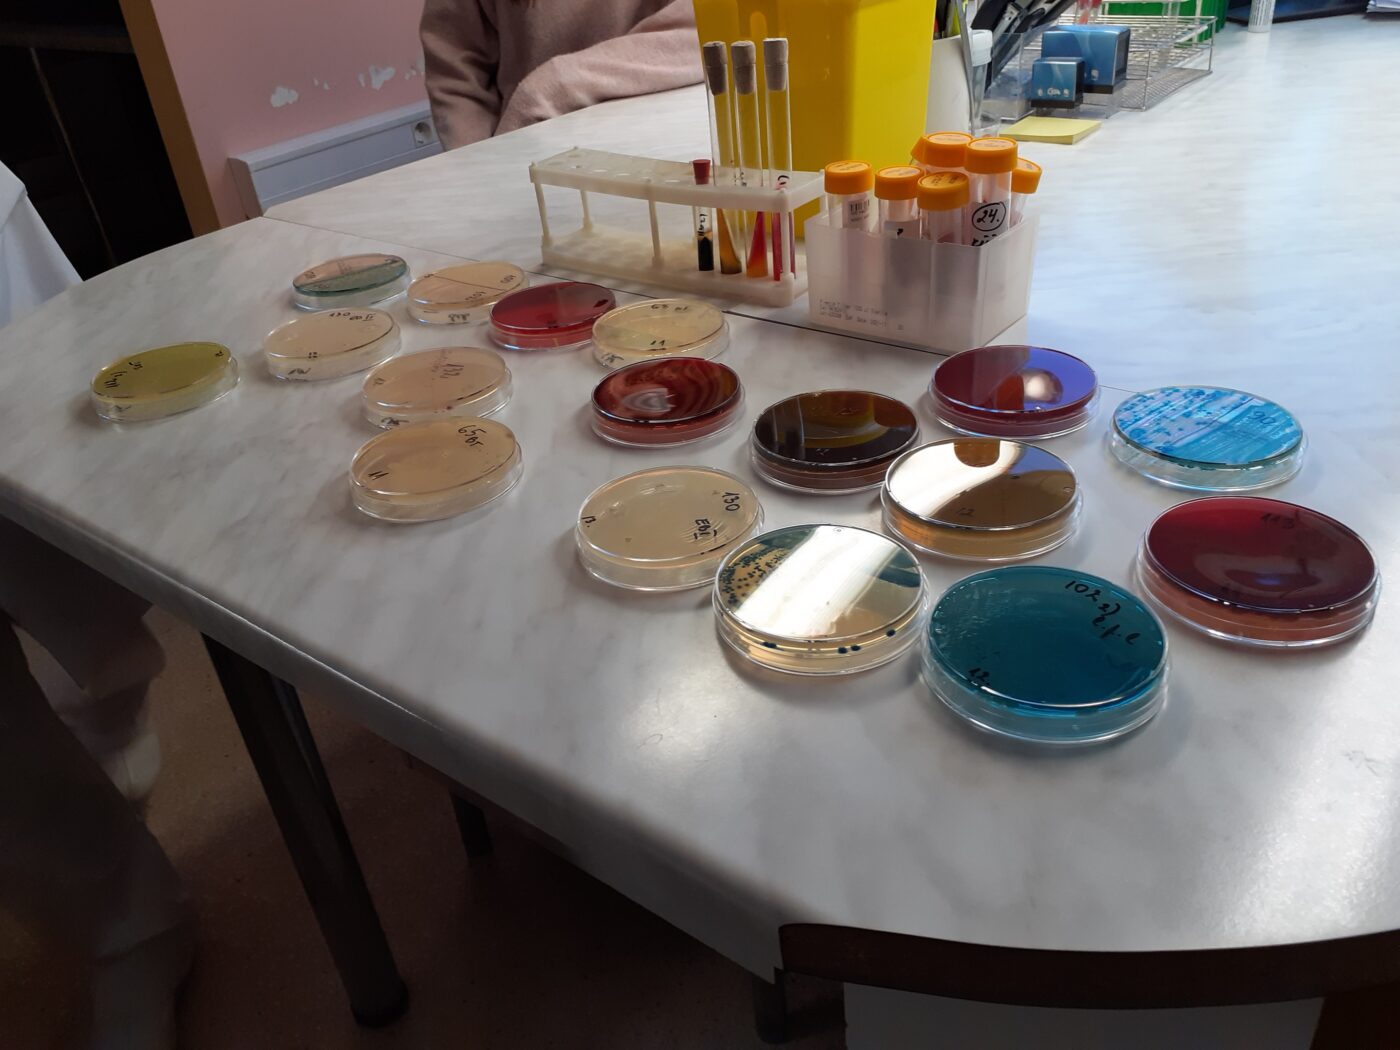

Loodusteaduste õppesuuna õpilased külastasid 14. jaanuaril Rakvere Haigla laborit. Tutvuti labori töökorraldusega ning saadi põhjalikum ülevaade verekeskusest, vererühmade määramisest ning selle vajalikkusest, vereseaduse olulisusest; samuti mikrobioloogia labori tööst – miks on tähtis kindlaks teha patsientide mikroobide kooslus; millised ohud valitsevad seoses nn haiglabakteritega; kui keeruline oli pandeemia aeg labori töötajatele jne. Oli võimalus tutvuda ka labori teiste osakondadega, kus näidati töötamist kaasaegsete analüüsiaparaatidega, millega bioanalüütikud määravad kindlaks proovide erinevad koostised, selgitati aparatuuri tööpõhimõtet, aga näidati ka mikroskoobi all inimese verepreparaate.
Sai selgeks, miks on tähtis konfidentsiaalsusleping ning kui oluline on täpsus ja korrektsus laborantide töös. Rakvere Haigla labor on hädavajalik abiline meie maakonna inimeste ja tervisekeskuste arstide jaoks.
Täname kõiki labori töötajaid, kes leidsid aega meie kooli õpilaste hariduse täiendamiseks, eriline tänu meie kooli vilistlastele, mikrobioloog Lele Liivile (33. lend), kes aitas õppekäiku organiseerida ning tutvustas verekeskuse tööd, ja laborandile Katrin Tikkerbärile (endine Mägi, 27. lend), kes näitas ja õpetas tööd verepreparaatidega. Soovime kõigile labori töötajatele edaspidiseks head tööindu ja jõudu!
Fotod ja tekst: Siret Pung, LOTE suunajuht